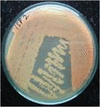

Table 2 Cultural characteristics of S. purpurascens MTCC 8547
Media | Color of mycelium | Spores | Reverse side | Pigment | |
|---|---|---|---|---|---|
ISP1 | Orange | White + | Orange | Orange |
|
ISP2 | Orange | White +++ | Orange | Orange diffusible |
|
ISP3 | Orange | White + | Orange | Orange diffusible |
|
ISP4 | Orange | White +++ | Orange | Orange diffusible |
|
ISP5 | Violet | White +++ | Violet | Violet |
|
ISP6 | Yellow | - | Yellow | Brown |
|
ISP7 | Pink | - | Pink | No |
|
PDA | Orange | White+++ | Orange | Orange |
|
SDA | Orange | White+++ | Orange | Reddish orange |
|